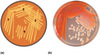

What unites are used to measure growth rate?
Generations / unit time
(doubling)
What is the approximate temperature range for the growth of a given organism?
30 ℃

What is a strict psychrophile? Where are they typically found?
A microbe with an optimal growth temperature around 15 ℃, with some as low as -20 ℃
Typically found in arctic soils, glaciers, and deep ocean environments
Do strict psychrophiles cause food problems?
No
What is a psychrotroph?
A microbe with an optimal growth temperature around 25 ℃
Do psychrotrophs cause food spoilage?
Yes; But its low temp food spoilage
What are some examples of psychrotrophs that commonly cause food spoilage in the fridge?
- Listeria monogenes*
- Clostridium botulinum*
What is a mesophile?
A microbe with an optimal growth temperature range of 25-40 ℃
Are mesophiles responsible for food spoilage?
Yes. Room temperature food spoilage
What is the optimum growth temperature for thermophiles?
50-60 ℃
Are thermophiles pathogenic?
Not particularly
What is the optimum growth temperature of hyper/extreme thermophiles?
>80℃
What type of microbe is Thermus aquaticus? Why is it commercially important?
Hyperthermophile
Used for its DNA polymerase (Taq polymerase) for lab use (i.e. PCR)
Optimal growth around 70-75C
Most bacteria grow in what pH range?
6.5 - 7.5
Most molds and yeasts grow in what pH range?
5 - 6
In hypertonic environments, an increase in sugar causes what to happen to a cell?
Plasmolysis

Halophiles survive in what type of environment?
High salt concentrates
What salt concentration can most ocean microbes survive in?
~3.5%
Slight halophiles
Facultative halophiles can survive at what salt concentration?
2% - 15 %
Extreme or obligate halophiles require what salt concentrations to survive?
10 - 30% (dead sea)
What concentration of salt inhibits most bacteria?
2%
What are the main chemical requirements for the growth of a microbe?
Carbon
Nitrogen
Sulfur
Phosphorus
Oxygen
Potassium Magnesium
Calcium
Trace elements
Organic growth factors
About 50% of the dry weight of a typical cell is _____
carbon
8% of the dry weight of E. coli is _____
Hydrogen